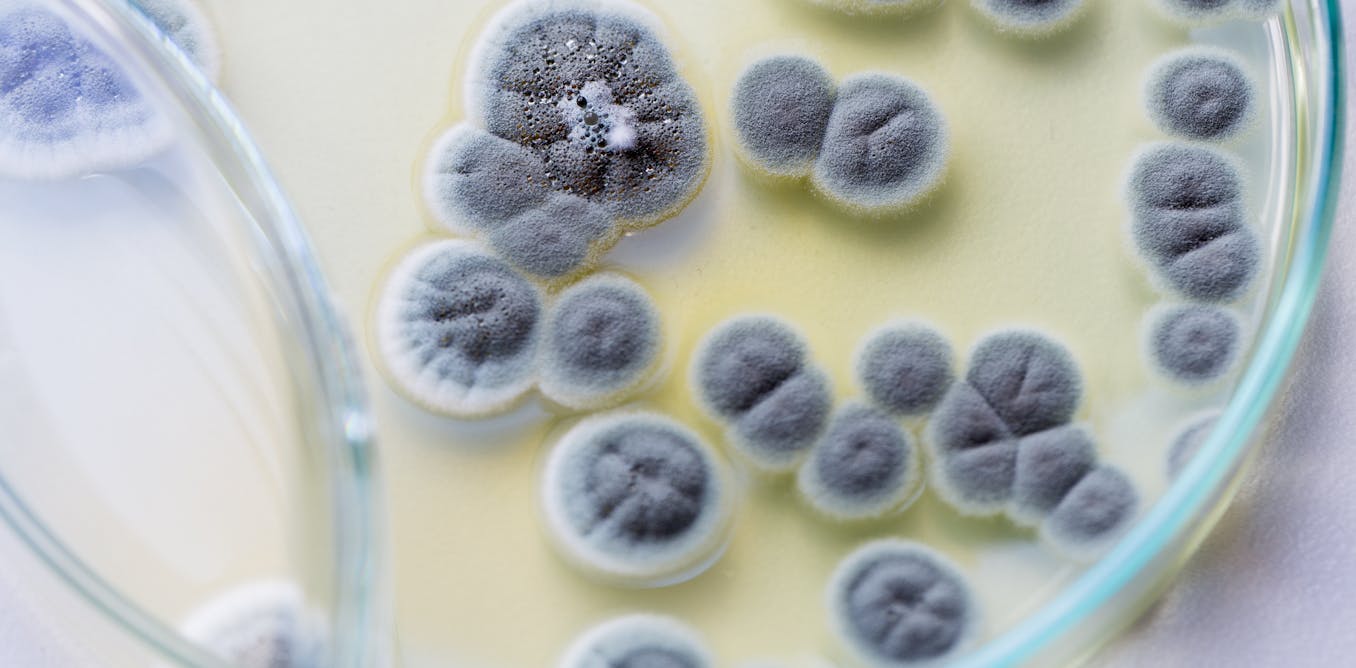

Biologists don’t call them “the hidden kingdom” for nothing. With an estimated 5 million species, only a mere 100,000 fungi are known to scientists. This kingdom, which includes molds, yeasts, rusts and mushrooms, receives far less attention than plants or animals. This is particularly true for fossils of fungi, most of which are discovered while hunting for more charismatic, at least to the eyes of some, plant fossils.
Fungi were key partners of plants during their colonization of land approximately 500 million years ago – an important and well-documented evolutionary transition. Therefore, it is unsurprising that the earliest fungal fossils, found in 450 million-year-old rocks, resemble modern species associated with the roots of plants. But that conflicts with DNA-based estimates, which suggest that fungi originated much earlier – a billion or more years ago. It’s a riddle in the tree of life that evolutionary biologists like me have long been puzzled about.
Fossils versus DNA
For years scientists have tried to reconcile the fungal fossil record with estimates from analyses of fungal DNA. But some of their key morphological characters – that is, the shapes they take – can only be established via microscopic and chemical analyses. That includes the complex networks of microscopic thread-like filaments and cell walls made of chitin, which are also not visible to the naked eye. The effort seemed hopeless, until now.
Corentin Loron, a graduate student at the University of Liege in Belgium and colleagues, discovered microscopic, fossilized specimens of a fungus called Ourasphaira giraldae in shale rock from the Grassy Bay Formation in the Northwest Territories of Canada. Given that Ourasphaira is found on 1,000- to 900-million-year-old rocks, the new fossil pushes back the origin of fungi by half a billion years.
A very revealing fossil
But how did Loron deduce that these fossils are fungi? While most of us are quite familiar with the large reproductive structures of some fungi, such as mushrooms, most of us are less familiar with the fungal network of microscopic thread-like filaments that makes up their “bodies.”
Microscopical analyses of Ourasphaira show that it formed a network just like those made by modern fungi; and chemical analyses show that the cell walls of these microfossils contain chitin, again just like modern fungi.
The implications of this discovery are twofold.
First, the fossil singlehandedly reconciles DNA-based and paleontological estimates of fungal origins, pushing back the origin of Opisthokonta, a supergroup comprising fungi, animals and their single-celled relatives to at least a billion years ago. And second, the fossil gives us clues about the environments where the first fungi lived. Ourasphaira was found in a shale, a type of rock that forms at the muddy bottom of lakes and rivers. Since this particular shale appears to have been formed as a result of sedimentation from a shallow-water estuary, it may be the first fungi evolved where rivers met the seas a billion years ago.
It’s one more clue that helps fill in the picture on how life on earth evolved and one more step toward bringing this fascinating group of organisms to the limelight.
Post a Comment